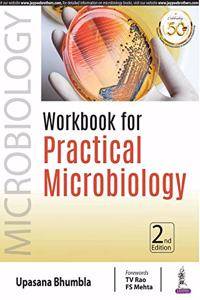
Workbook for Practical Microbiology

Only logged in customers who have purchased this product may leave a review.
Sale!
Workbook for Practical Microbiology (Paperback) | Released: 30 Sep 2018
By: Upasana Bhumbla (Author) Publisher: Jaypee Brothers Medical Publishers5.00% Off Original price was: ₹ 695.00.₹ 660.00Current price is: ₹ 660.00.
You save ₹ 35.00
A workbook for the practical exercises in microbiology. The book teaches concepts in a workbook style so that the students are able to understand and write the practical notes. Recent advances that are increasingly applied in the rapid diagnosis of infectious diseases are included. Read More
In stock
Ships within 1-2 Business Days
100% Orginal Books
Easy Replacement
Certified product
Secure Checkout
On time delivery
Author:
Upasana Bhumbla
Publisher Name:
Jaypee Brothers Medical Publishers
Language:
Binding:
(Paperback)
About The Book
A workbook for the practical exercises in microbiology. The book teaches concepts in a workbook style so that the students are able to understand and write the practical notes. Recent advances that are increasingly applied in the rapid diagnosis of infectious diseases are included.

Reviews
There are no reviews yet.